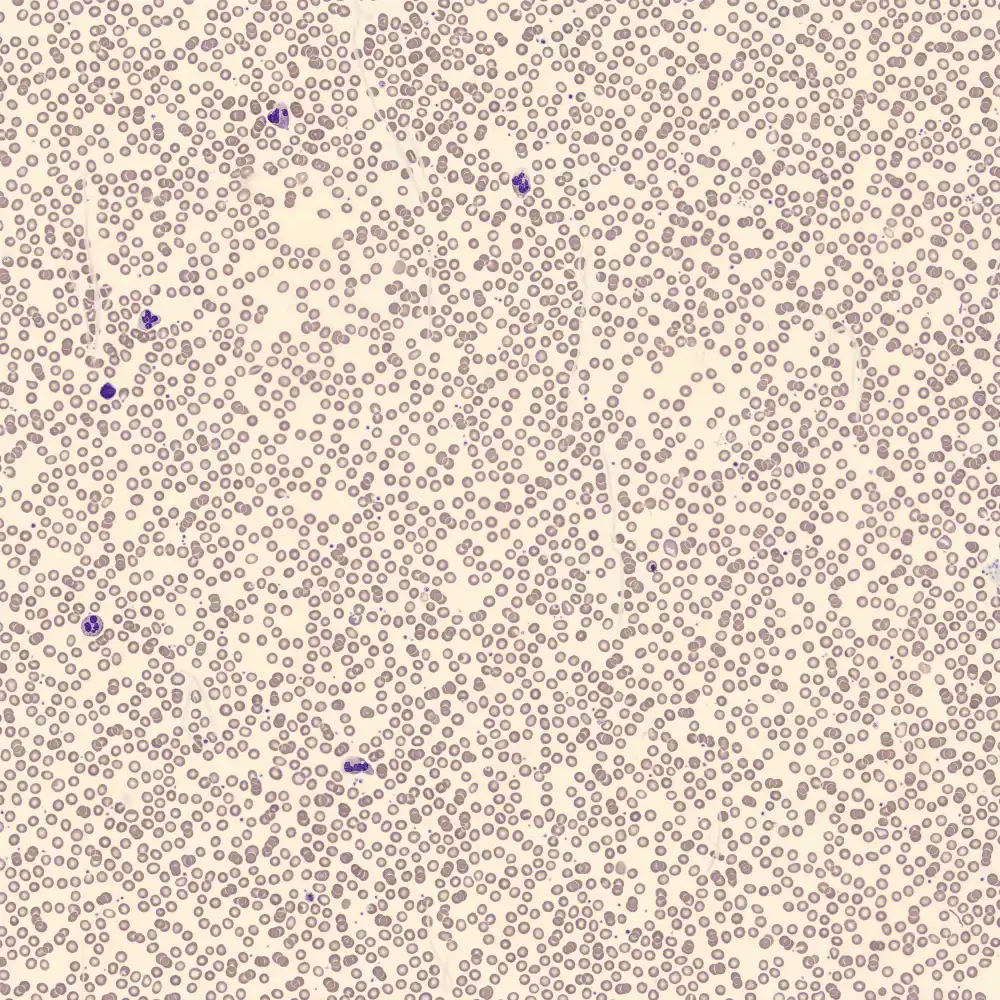

WDF - Fibrin
SFL
SSC

Lymphozyten
Monozyten
Neutrophile
Eosinophile
Basophile
In dieser Probe zeigt das WDF-Diagramm eine blaue Färbung, die von der Trümmerregion zwischen den neutrophilen und eosinophilen Granulozyten ausgeht . Diese zusätzliche Population ist auf das Vorhandensein von Fibrinfilamenten in der Probe zurückzuführen.
Im WDF-Kanal können Fibrinfilamente teilweise fluoreszieren und Streuung erzeugen, wodurch sie als längliche, diffus begrenzte Population sichtbar werden. Dies ist ein präanalytisches Artefakt, das in der Regel auf eine unzureichende Durchmischung, eine verzögerte Verarbeitung oder eine teilweise Koagulation der Probe zurückzuführen ist.
Mögliche Morphologie